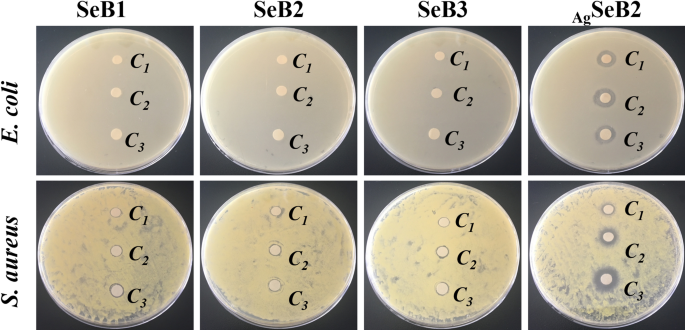
figure 10

Abstract
Selenium-doped nanostructure has been considered as an attractive approach to enhance the antibacterial activity of calcium phosphate (CaP) materials in diverse medical applications. In this study, the selenium-doped biphasic calcium phosphate nanoparticles (SeB-NPs) were first synthesized. Then, silver was in situ incorporated into SeB-NPs to obtain nanostructured composite nanoparticles (AgSeB-NPs). Both SeB-NPs and AgSeB-NPs were characterized by Fourier transform infrared spectroscopy (FT-IR), X-ray diffraction (XRD), ultraviolet–visible spectroscopy (UV–Vis), X-ray photoelectron spectroscopy (XPS), and Raman spectra. The results confirmed that the SeO32− was doped at the PO43− position and silver nanoparticles were deposited on the surface of SeB-NPs. Next, Transmission Electron Microscopy (TEM) analysis displayed that the prepared AgSeB-NPs had a needle-cluster-like morphology. CCK-8 analysis revealed SeB-NPs and AgSeB-NPs had good cytocompatibility with osteoblasts. The antibacterial activity of the prepared AgSeB-NPs was confirmed by using Gram-negative E. coli and Gram-positive S. aureus. The above results manifested the significance of the final AgSeB-NPs for biomedical applications.
Similar content being viewed by others

Introduction
Tissue engineering has been widely used in bone graft and dentistry due to a large number of patients require grafting resulting from congenital conditions, trauma, and tumor resection, and so on1,2,3. Mineralized tissues, such as bone, tooth enamel, dentin, and cementum, are enriched with significant amounts of ionic substitutions, including sodium, potassium, and carbonate groups. These elements can affect the functionality of related tissues4,5. Calcium phosphate (CaP) based nanoparticles, including hydroxyapatite (Ca10(PO4)6(OH)2, HA), β-tricalcium phosphate (Ca3(PO4)2, β-TCP), tetracalcium phosphate (Ca4(PO4)2O; TTCP), biphasic calcium phosphate (BCP), and so forth, were well-known in implant surgery because of their excellent biocompatibility, biodegradability, and tunable physicochemical properties. Compared to HA or β-TCP, biphasic calcium phosphate (BCP) composed of HA and β-TCP, performed better mechanical properties, higher biological activity, and adjustable degradation rate6,7,8,9,10. Bacteria attached to the implanted medical devices or scaffold can cause healthcare-associated infections, such as the formation of biofilm, which further results in local inflammation and infection. Therefore, the scaffold with excellent antibacterial properties provides an overwhelming advantage in the clinic stage11,12.
Many metal nanoparticles, such as silver (Ag), zinc oxide (ZnO), and titanium dioxide (TiO2), performed strong antibacterial properties and low toxicity towards mammalian cells, some of these nanoparticles have been widely applied in a range of areas13,14,15,16,17,18,19,20. Silver (Ag) is stable in the body fluids and can be used in antibacterial implants due to silver can easily binds to bacterial DNA and RNA, resulting in bacteria death21. However, the antibacterial effect of nanoparticles was influenced by size, shape, nanostructure, as well as chemical modification. Furthermore, it has been reported that substitution of metal ions in CaP based nanoparticles also showed powerful antibacterial effects, such as selenium-substituted hydroxyapatite (Se-HA) nanoparticles22. Se-HA nanoparticles not only displayed excellent biocompatibility but also inhibited specific bacterial strains of interest23,24. Matesanz et al. demonstrated that the osteoblasts-like cells and preosteoblasts-like cells could adhere to and proliferate on the Se-HA based scaffold, which leads to enhance osteogenesis ability compared to HA-based nanocomposites25.
Moreover, selenium (Se) is an essential element for the human body. Adults require 50–70 µg of selenium per day to make selenoproteins, which play a vital role in the human antioxidant defense system and redox control of cellular reactions26. Importantly, intaking low selenium increases the risk of mortality, poor immune function, and cognitive decline. Selenium can penetrate bacteria cells, catalyze the oxidation of intracellular thiols, and generate the singlet oxygen, which further causes the death of bacteria27,28. Besides bacteria inhibition, selenium doped nanoparticles also show effective anti-cancer properties29. However, the synergistic effect of silver and selenium on CaP based nanoparticles in inhibiting bacteria needs to be further investigated.
Here, for the first time, the nanostructured selenium-doped BCP nanoparticles with in situ incorporated silver (AgSeB-NPs) were fabricated via an easy and rapid precipitation method. First, selenium-doped BCP nanoparticles (SeB-NPs) were synthesized, and then, silver was deposited on SeB-NPs to obtain AgSeB-NPs (Fig. 1a). The physicochemical properties of the prepared nanoparticles were characterized by Fourier transform infrared spectroscopy (FT-IR), X-ray diffraction (XRD), ultraviolet–visible spectroscopy (UV–Vis), X-ray photoelectron spectroscopy (XPS), Raman spectra, and transmission electron microscopy (TEM). Next, the cytocompatibility of the prepared nanoparticles was evaluated by culturing with osteoblasts. Due to the positively charged AgSeB-NPs nanoparticles (silver ions), the bacteria cell membrane was destroyed, and the enzyme was inactivated until bacteria die, as shown in Fig. 1b. Thus, the antibacterial activity against Gram-negative E. coli and Gram-positive S. aureus was lastly investigated, and the results proved that the prepared AgSeB-NPs had the potential for antibacterial application in tissue engineering.
Materials and methods
Materials
Sodium selenite (Na2SeO3, 97.0%) was purchased from Shanghai Tyrael Chemical, Co., Ltd. Ammonium phosphate dibasic ((NH4)2HPO4, 99.0%) was obtained from Shanghai Macklin Biochemical Co., Ltd. Calcium nitrate tetrahydrate (Ca(NO3)2·4H2O, 99.0%) was purchased from Sinopharm Chemical Reagent Co., Ltd. Silver nitrate (AgNO3, 99.8%) was obtained from Tianjin Tiangan Chemical Technology Development Co., Ltd. Ammonium solution ( NH3·H2O, 25–28%) was purchased from Ron Reagent Co., Ltd. Ultrapure water was prepared by a Milli-Q50 SP Reagent Water System (Millipore Corporation, MA, USA). The chemicals used in this study were all analytical grade procured from commercial sources, without further purification.
Preparation of selenium-doped biphasic calcium phosphate nanoparticles (SeB-NPs)
The SeB-NPs were prepared according to our previous reports with modification30,31. Briefly, 50 mL mixed solution of (NH4)2HPO4 and Na2SeO3 was added in a three-neck flask (different SeB-NPs samples was synthesized mainly depend on adjusting the molar concentration of (NH4)2HPO4 and Na2SeO3, Electronic Supplementary Material, Table S1), and 50 mL solution of Ca(NO3)2·4H2O (1.69 M) was added, then the pH of mixed solution in the flask was adjusted to 11.0 by adding ammonium solution. The mixed solution was stirred for 24 h, and the precipitates were collected by centrifugation (10,000 rpm) and washed using Millipore water five times. The precipitates were dried at 60 °C for 24 h to obtain SeB-NPs powder. Different SeB-NPs (SB1, SB2, and SB3) were synthesized by adjusting Ca/(P + Se) and Ca/Se mole ratios, as shown in Table 1. At the same time, biphasic calcium phosphate nanoparticles (BCP-NPs) and selenium-doped hydroxyapatite nanoparticles (SeHA-NPs) were prepared for comparison (Electronic Supplementary Material).
Preparation of SeB-NPs with incorporation of silver (AgSeB-NPs)
200 mg of SB3 nanoparticles was dispersed in 100 mL Millipore water in a three-neck flask, and 30 mg of AgNO3 was added into flask slowly. The solution was stirred for 3 h at room temperature (RT). The precipitates were collected by using centrifugation (10,000 rpm) and washed five times using Millipore water to obtain AgSeB-NPs. Different AgSeB-NPs samples were fabricated by regulating the amount of AgNO3, as shown in Table 2.
Physicochemical characterization of SeB-NPs and AgSeB-NPs
Fourier transform infrared spectroscopy (FT-IR) analysis
FT-IR (ThermoFisher, Nicolelis5) was used to confirm the presence of specific chemical groups in SeB-NPs and AgSeB-NPs. The nanoparticles powders were mixed with KBr, ground, and pressed into thin sections, and the KBr was measured as blank control. FT-IR spectra were obtained within the range between 4,000 and 500 cm−1 with a resolution of 1 cm−1.
X-ray diffraction (XRD) analysis
Both SeB-NPs and AgSeB-NPs powders were analyzed by X-ray diffraction (XRD). A X-ray diffractometer (Rigaku Smartlab 9 kW), operating at 45 kV and 200 mA with Cu Kα radiation (λ = 1.5406 Å) and a spinning sample holder, was used to collect the X-ray powder diffraction (XRD) patterns. Data were acquired in the 2θ range of 10°–90° at a step increment of 0.05°.
Ultraviolet–visible spectroscopy (UV–Vis) analysis
To investigate the diffuse reflectance spectra of samples, Ultraviolet–visible Spectroscopy (UV–Vis, PerkinElmer, Lambda 950) was used. This instrument was equipped with an integrating sphere attachment. The sample was operated in the range of 200–800 nm at 298 K for the optical diffuse reflectance (DRS) spectra.
Dynamic light scattering (DLS) analysis
The size distribution of nanoparticles was examined by Dynamic Light Scattering (DLS, Malvern Zetasizer 3000E). Zeta potential measurements were performed by Laser Doppler Anemometry with a Zetasizer Nano ZS/Masterszer 3000E. Electrophoretic mobility (converted into ζ-potential by the Smoluckowsky approximation) of nanoparticles was tested at 25 °C.
Morphology analysis
The morphology of SeB-NPs and AgSeB-NPs was investigated by Transmission Electron Microscopy (TEM, Tecnai G2 F20) with an energy-dispersive detector (EDS) and Elemental Mapping accessories. The obtained nanoparticles were dispersed in ethanol and sonicated for 2 h, and then the copper grid was dipped into a sample solution and dried under an infrared lamp. Furthermore, the morphology of SeB-NPs and AgSeB-NPs were observed with a cold field emission scanning electron microscope (SEM, Hitachi, S-4800). Before SEM observation, the samples were coated with a thin Pt conductive layer, energy dispersive X-ray Spectroscopy (EDX) was used for the elemental composition analysis or chemical characterization.
Raman spectroscopy analysis
Raman spectra of both SeB-NPs and AgSeB-NPs were recorded with a Spex Model spectrometer (LabRAM HR) from 200 to 1,600 cm−1 using the 488 nm wavelength excitation from an argon-ion laser.
X-ray photoelectron spectrometer (XPS) analysis
Both SeB-NPs and AgSeB-NPs were also measured by X-ray Photoelectron Spectrometer (K-Alpha 0.05 eV, Thermo Scientific) to obtain their elements composition, the detailed sample preparation for XPS test refers to our previous paper6.
Cell culture and cytocompatibility of SeB-NPs and AgSeB-NPs
Regarding the potential bone tissue engineering application in the future, hFOB 1.19 cell (osteoblast type, ATCC® CRL-11372™) was used to evaluate the cytocompatibility of SeB-NPs and AgSeB-NPs. According to ATCC protocols, hFOB cells were cultured using Dulbecco’s modified Eagle’s medium (DMEM) (Sigma-Aldrich) supplemented with 10% fetal bovine serum, 100 U mL−1 penicillin, and 100 μg mL−1 streptomycin. Cells were grown in the tissue culture flask (50 mL) under a humidified atmosphere of 95% air and 5% CO2 at 37 °C. The culture medium was changed every 2 days. The cells were passaged by trypsinization, and cells at passage 5 were used for the next experiments. First, a certain amount of obtained SeB-NPs and AgSeB-NPs were added into the cell medium, and no agglomeration phenomenon was not observed under optical microscopy. The cell viability cultured with nanoparticles was quantitatively investigated by the Cell Counting Kit-8 (CCK-8, Abcam) assay, and the CCK-8 assay was operated according to the CCK-8 Cell Proliferation Assay Kit protocol. Finally, the absorbance at 450 nm was measured by using a microplate reader to indicate cell proliferation after culturing with nanoparticles (Electronic Supplementary Material).
Antibacterial activity assay
Gram-negative E. coli (ATCC 25922) and Gram-positive S. aureus (ATCC 6538) were used to evaluate the antibacterial activity of prepared SeB-NPs and AgSeB-NPs. The single colony of E. coli and S. aureus on the Luria Bertani (LB) agar plate were transferred to a liquid LB culture medium by growing at 37 °C overnight to obtain seed culture. 100 μL of nanoparticles dispersed in ultrapure water (the concentrations of nanoparticles used were 500 μg/mL, 1,000 μg/mL and 2000 μg/mL, respectively) were mixed with 10 mL autoclaved LB medium, then 5 μL of seed cultures of E. coli or S. aureus was inoculated into the medium. After culturing for 12 h at 37 °C, the optical density at 600 nm (OD600) was tested by a UV–Vis spectrophotometer. E. coli and S. aureus were grown at the same conditions without adding nanoparticles as the control group. On the other hand, the seed culture medium was diluted into fresh LB medium and cultured under 37 °C. When the OD600 of medium reached about 0.6, the broth was diluted to 105 CFU mL−1 with sterile 0.9% NaCl solution. After then, the suspension (50 μL) was spread onto a 90 mm-diameter LB agar plate. The wells were created with a hole puncher with a diameter of 4 mm. 30 μL of the prepared nanoparticles solutions (500 μg/mL, 1,000 μg/mL and 2000 μg/mL) were added into the wells. Then, the plates were kept in an incubator at 37 °C for 12 h, the inhibition zones for each sample were recorded.
Statistics
All data were expressed as means with standard deviation. SPSS software (SPSS Inc, Chicago IL) was used for the analysis. Statistical analyses were performed by ANOVA or 2-way repeated-measures ANOVA with Tukey’s test applied to investigate specific differences. Statistical significance was defined at a p value of < 0.05 for 95% confidence.
Results
Physicochemical characterization
First, the chemical groups were analyzed by FT-IR spectroscopy, and the spectra of SeB-NPs and AgSeB-NPs were presented in Fig. 2. The broad peak in the range of 3,000–3,800 cm−1 was due to H2O stretching vibrations in absorbed water. As shown in Fig. 2a, the band at 3,572 cm−1 was arisen from the stretching of OH− ions. The bands for BCP at 1,107, 1,136, and 962 cm−1 corresponded to the P–O stretching vibration modes of PO43−, while for SeB-NPs it decreased and disappeared. At the same time, the band at 563 cm−1 was attributed to O–P–O vibration mode, and the band decreased as the Ca/Se ratio increased. Notably, the sharpness of 563 cm−1 bands indicated the well-crystallized BCP-NPs, and the peak became rounded, indicated the decrease of crystallization for Se-NPs. However, due to the incorporation of selenium, a band of SeB-NPs at 871 cm−1 appeared, which was assigned to SeO32− stretching. The spectra of AgSeB-NPs were shown in Fig. 2b. It was clearly noted that the peak at 1,035 cm−1 was ascribed to antisymmetric (v3) P-O stretching vibration mode, which was mainly due to the combination of the silver nanoparticles with OH− or PO43− groups of SeB-NPs. The slight difference between AgSeB1, AgSeB2, and AgSeB3 demonstrated that the chemical bonding between silver and SeB-NPs barely happened, and silver was mainly deposited on SeB-NPs via electrostatic attraction. Complementary to the above FT-IR analysis, the Raman spectra of both SeB-NPs and AgSeB-NPs were obtained.
The Raman spectra of SeB-NPs and AgSeB-NPs were shown in Fig. 3. The OH−1 vibrational bands in the region of 630 cm−1 were not clearly observed, which was in good accord with the FT-IR results. In the case of SeB-NPs, an intense peak appeared at 960 cm−1 due to the stretching mode (v1) of PO43− group, and peaks at 430 cm−1, 590 cm−1, and 1,070 cm−1 were attributed to the stretching mode (v2), bending mode (v4), and stretching mode (v3) of the PO43− group, respectively. The peak at 1,064 cm−1 corresponded to the symmetrical stretching vibration mode (v1) of CO32− group. In addition, the band near 830 cm−1 was attributed to the symmetrical stretching mode (v1) of the SeO32− group. For AgSeB-NPs, similar chemical groups from SeB-NPs appeared. Compared with FTIR spectra, water vibrational modes should give rise to weak intensity stretching and no bending bands in Raman spectra were observed. However, the intensity of the vibration peak at 589 cm−1 increased with increasing silver content.
XRD was used to identify the crystalline phase, and the XRD patterns of all of the synthesized samples were shown in Fig. 4a. The peaks of HA and β-TCP were present in BCP, SeB-NPs, and AgSeB-NPs, the peaks at 25.9° (0 0 2), 28.2° (1 0 2), 31.8° (2 1 1), 32.3° (1 1 2), and 49.6° (2 1 3) matched with the standard XRD spectrum of HA (JCPDS No. 9-0432), and the peaks at 22.9° (3 3 -2), 25.9° (1 0 10), 28° (2 1 4), and 31.4° (2 1 10) matched with β-TCP (JCPDS, No. 9-0169). The peaks in the (0 0 2) and (2 1 1) planes were broadened for SeB-NPs, indicating that selenium might enter into the crystal lattice of BCP-NPs and affect the crystallinity of BCP-NPs. Furthermore, the broadening of reflection peaks in XRD patterns for SeB-NPs indicated that the decrease of crystallinity with the increase of Ca/Se ratios, which may be due to the substitution of PO43− by SeO32− group. With increasing selenium content into BCP-NPs, the crystallinity of SeB-NPs decreased. For AgSeB-NPs, no other crystalline phases were detected based on SeB-NPs. The reduced intensity indicated that the crystallinity further decreased gradually with increasing silver content. It was notable that new peaks (2θ = 35–40°) were emerged AgSeB-NPs compared to SeB-NPs, and Bragg reflections corresponding to silver were detected (2θ = 38.2° and 44.4°, JCPDS, No. 87-0720, Supplementary Materials).
Furthermore, the UV–Vis DRS spectroscopy was used to analyze the obtained AgSeB-NPs, as shown in Fig. 4b. The UV–Vis DRS absorption broadened in the region of 250–800 nm, and the band at 550 nm corresponds to the surface plasmon resonance of silver nanoparticles. This phenomenon indicated that silver was deposited uniformly on SeB-NPs. To get a further detailed vision for the ionic species of SeB-NPs and AgSeB-NPs, XPS measurements were performed, as shown in Fig. 5. The XPS spectra of SeB-NPs (Fig. 5a–c) found all the expected elements during the preparation process, including Ca, O, C, P, Se. The peak at 58 eV corresponded to SeO32− [Se (IV)] indicated that SeO32− group was already incorporated in BCP-NPs lattice. And the peak at 55 eV belonged to Se (0) was not observed, proving that the redox reaction happened during the preparation process. The P2p spectra of all samples exhibited a peak at 132 eV, which was assigned to the phosphate group. The double peaks at 347 eV and 351 eV were attributed to the Ca2p3/2 and Ca2p1/2. For AgSeB-NPs, except for the peaks appeared in SeB-NPs, the new high peaks around 367 eV and 373 eV were assigned to Ag3d5/2 and Ag3d3/2 binding energies, respectively32,33.
The morphology of the prepared SeB-NPs and AgSeB-NPs was analyzed by TEM. TEM micrographs of SeB-NPs were given in Fig. 6. BCP-NPs exhibited an ellipsoidal morphology (Figure S1, Supplementary Materials). SeB-NPs showed clear needle granular morphology with a length of less than 100 nm. The results revealed that the doping selenium influenced the morphology of SeB-NPs. Agglomeration was observed in all SeB-NPs samples. SEM was used to further confirm the morphology of SeB-NPs, and the SEM images were shown in Figure S2a–f (Supplementary Materials), and the nanoparticles of all samples were aggregated. With increased Ca/Se mole ratio, more SeB-NPs nanoparticles aggregated, which was certified via DLS analysis (Figure S3, Supplementary Materials). Furthermore, the high-angle annular dark-field (HAADF) mode image of sample SeB2 was present in Fig. 6d, which was inserted in the top-left corner, and the elemental mapping results were shown in Fig. 6e–g. The presence of calcium (yellow), phosphorus (blue), and selenium (green) indicated that selenium was evenly distributed in the SeB-NPs.
TEM images of the prepared SeB-NPs, (a): SeB1, (b): SeB2, (c): SeB3, the image inserted at the top-right corner of the image (b) was enlarged to a higher magnification. Elemental mapping of SeB2 (d) revealed the presence of calcium (e), phosphate (f), and selenium (g), the image inserted at the top-left corner of the image (d) was acquired High-angle annular dark-field (HAADF) image.
The TEM images of AgSeB-NPs were displayed in Fig. 7. Compared with SeB-NPs, the AgSeB-NPs displayed irregular morphology, and the aggregation was observed, indicating that the morphology of SeB-NPs was influenced by the deposition of silver nanoparticles. According to the DLS test results (Figure S3c, Supplementary Materials), multiple peaks appeared and confirmed that AgSeB-NPs nanoparticles were further aggregated compared to SeB-NPs, which was also affirmed by SEM (Figure S2g–i, Supplementary Materials). With the increase of AgNO3 used during the preparation procedure, the prepared AgSeB-NPs tended to flock together, and the snowflake-like morphology was shown (Fig. 7d). The high-magnification image of AgSeB2 revealed that the silver nanoparticles adhered to the surface of AgSeB-NPs (Fig. 7c). Interestingly, a rooster-like image (like the map of China) was obtained for AgSeB2 sample, as shown in Fig. 7e, and the HAADF mode image was inserted in the bottom-right corner. The elemental mapping analysis showed that silver (red, Fig. 7f), calcium (yellow, Fig. 7g), phosphorus (blue, Fig. 7h), and selenium (green, Fig. 7i) were detected, proved that silver and selenium were evenly distributed in AgSeB-NPs. In addition, EDX analysis was used to further determine the elemental composition of SeB-NPs and AgSeB-NPs, as shown in Figure S4 (Supplementary Materials). According to the EDX analysis of SeB-NPs, the elements oxygen (O), phosphorous (P), calcium (Ca), and selenium (Se) were presented. With increasing Ca/Se mole ratio, the weight percent of selenium calculated from EDX decreased. The weight percentage of silver were 0.06, 0.13, and 0.33 for AgSeB1, AgSeB2, and AgSeB3, respectively, which was consistent with the amount of AgNO3 added during the preparation of AgSeB-NPs.
TEM images of the prepared AgSeB-NPs, (a): AgSeB1, (b, c, e): AgSeB2, (d): AgSeB3, the image (c) was enlarged from image (b) at a higher magnification. Elemental mapping of AgSeB2 (e) confirmed the presence of silver (f), calcium (g), phosphate (h), and selenium (i), the image inserted at the bottom-right corner of the image (e) was HAADF image.
In vitro cytocompatibility
The in vitro cytocompatibility test of the prepared SeB-NPs and AgSeB-NPs is an essential prerequisite for future bone tissue engineering, and biological experiments were conducted by using hFOB 1.19 cell as the cell model. Figure 8 showed the CCK-8 assay results after the hFOB 1.19 cells cultured with SeB-NPs and AgSeB-NPs for 1 and 3 days. The degree of hFOB 1.19 cells growth was recorded by the absorbance at 450 nm. For all prepared nanoparticles, the number of cells increased with the number of culture days indicated that the obtained nanoparticles had an excellent cytocompatibility. However, the cell number decreased with increasing the concentration of nanoparticles from 50 µg/mL to 2000 µg/mL. The cell morphology on day 3 was investigated using optical microscopy and fluorescent microscopy (FITC-Phalloidin/DAPI staining) and 2000 µg/mL of nanoparticles were used (Figures S5 and S6, Supplementary Materials). The cells incubated with the prepared nanoparticles showed a well-preserved morphology, which was polygonal and fully spread. Moreover, the cells proliferated with AgSeB-NPs faster, than that with SeB-NPs. There were no statistically significant differences in cell proliferation culturing with different samples.
Antibacterial test
The antibacterial activity of the prepared SeB-NPs and AgSeB-NPs against Gram-positive S. aureus and Gram-negative E. coli bacteria was systematically evaluated, and the results were shown in Figs. 9 and 10. S. aureus could cause the formation of biofilm on bone implants, and E. coli strains possess the reduction capability of selenite. Thus, both bacteria were used here. The optical density at 600 nm (OD600) values of S. aureus and E. coli by adding SeB-NPs and AgSeB-NPs using different concentrations were presented in Fig. 9. Compared with the control group, the doping selenium into BCP-NPs had slight influence on the antibacterial activity, and it had a slight inhibitory effect against bacteria of SeB-NPs after 12 h of culture. However, the proliferation of both S. aureus and E. coli was completely suppressed by AgSeB-NPs. The photos and inhibition ratio of E. coli and S. aureus grown in the actual culture tubes after adding SeB-NPs and AgSeB-NPs after 12 h were shown in Figures S7 and S8 (Supplementary Materials). Furthermore, the OD600 values of S. aureus after SeB-NPs were lower than that of E. coli, indicated that SeB-NPs had a better antibacterial effect against S. aureus than E. coli. For AgSeB-NPs, the inhibition ratio of both S. aureus and E. coli increased with the increase of the AgNO3 dosage. There were no differences in AgSeB-NPs against both bacteria. The antibacterial activity of nanoparticles was also confirmed by bacteriostatic circles investigation as shown in Fig. 10.
The disk diffusion was used to confirm the antibacterial effect of prepared SeB-NPs and AgSeB-NPs dispersed in ultrapure water against bacterial colonies. Photos of bacteriostatic circles for nanoparticles using different concentrations were recorded, as shown in Fig. 10. For SeB-NPs, the bacteriostatic circles of E. coli were not apparently observed, and such circles of S. aureus appeared, in which the concentration of nanoparticles did not have a significant influence on the diameter of circles. However, compared with SeB-NPs, AgSeB-NPs have significant inhibition circles against S. aureus and E. coli. The antibacterial activity of AgSeB-NPs against E. coli was not influenced by the concentration. But, such activity against S. aureus increased with increasing of AgSeB-NPs concentration, demonstrated a dose-dependent manner. Furthermore, both SeB-NPs and AgSeB-NPs displayed better antibacterial properties compared to selenium-doped hydroxyapatite (SeHA-NPs) (Figures S9and S10, Supplementary Materials).
Discussion
The stated objective of this study was to synthesis new-style biphasic calcium phosphate nanoparticles (BCP-NPs) with excellent cytocompatibility and antibacterial activity for further hard-tissue engineering applications. Recently, silicon, silver, copper, zinc, selenium, iron, lithium, and titanium dioxide, et al., have been employed to mingle with bone scaffolds to improve their physicochemical properties34,35,36,37,38,39,40. Such as, silicon could be doped into hydroxyapatite and composited into gelatine, and then, the three-dimensional (3D) printable composites were obtained. The porous scaffold could be fabricated by rapid prototyping at room temperature (RT)39. The bone regeneration of bioactive silicate glass could be improved when the copper was doped at a controlled concentration (0–0.8 wt.% copper oxide), while displayed a promising antibacterial activity41. Furthermore, compared with pure hydroxyapatite (HA) scaffold, lithium-doped hydroxyapatite scaffold not only showed a higher degradation rate but also benefit the proliferation of osteoblasts42. Ahmed et al. confirmed that the introduction of selenium into carbonated hydroxyapatite (CHAP) could increase the diffusion and infiltration of human fibroblasts on CHAP based scaffold34. Developing a multifunctional scaffold, which combines excellent biocompatibility, osteoinductivity, and antibacterial ability, which is considered to be the next-generation orthopedic implants for hard tissue engineering applications43,44. Selenium, silver, and antibacterial drugs, such as cephalexin and chlorhexidine, were commonly used to impart antibacterial function to the composite scaffolds45,46,47,48. Nguyen et al. investigated that selenium nanoparticles could inhibit Staphylococcus aureus, with low toxicity to mammalian cells49. Wang et al. identified that after coating poly(ether ether ketone) (PEEK) medical devices with selenium nanoparticles, the growth of Pseudomonas aeruginosa could be significantly inhibited29. However, the uncontrolled release of drugs, the potential systemic toxicity of medicine, and the aggregation of nanoparticles hindered the potential functions of the scaffolds. For these reasons, drugs with selenium, and silver were mainly encapsulated, or mixed, coated into the scaffold50,51. Here, we first fabricated the selenium-doped biphasic calcium phosphate nanoparticles, which were incorporated with silver nanoparticles.
The physicochemical properties of the obtained AgSeB-NPs were deeply characterized by FT-IR, XRD, UV–Vis, Raman, and XPS analysis. In this study, SeB-NPs were synthesized by co-precipitation and ion-exchange sorption, aka, post-precipitation, occurred simultaneously. By substituting PO43− on the surface of BCP-NPs to adsorb SeO32− group, then a port of SeO32− ions entered the lattice (HA or β-TCP)52. The addition of selenium dopant could influence the phase composition, and the resulting SeB-NPs could be tentatively represented as Ca10(PO4)X(SeO3)(6-X)(OH)2 + Ca3(PO4)X(SeO3)(6-X). The FT-IR spectra of SeB-NPs and BCP-NPs showed the v1 + v3 phosphate vibration in the region of 1,200–900 cm−1 and v4 phosphate bands in the range of 650–500 cm−1, as shown in Fig. 2a53. The O-Se-O asymmetric bond stretching at 731 cm−1 was detected for SeB-NPs, and the SeO32− group at 783 cm−1 was measured as well. With decreased Ca/Se mole ratio, the peaks belonging to the SeO32− group became stronger, which confirmed the presence of SeO32− group in SeB-NPs54. After XPS analysis of SeB-NPs, there was one peak at 58 eV of the Se3d scanning, which also proved that only SeO32− [Se (IV)] instead of SeO43− [Se (VI)] was incorporated into SeB-NPs (Fig. 5).
However, after the deposition of silver nanoparticles on the surface of SeB-NPs, no chemical bonds were formed between silver and SeB-NPs (Figs. 2, 3). Next, the crystallinity of SeB-NPs and AgSeB-NPs was evaluated by XRD, as shown in Fig. 4a. The appearance of HA and β-TCP in all samples was expected. The relative intensity of the diffraction peak at 25.9° (0 0 2) (D(002), Miller’s plane) was chosen to calculate the crystallite size (Scherrer equation)55,56. The crystallite means size varied for BCP-NPs, SeB-NPs, and AgSeB-NPs, were calculated by Scherrer equation (Supplementary Materials). Compared with BCP-NPs, the unit cell dimensions of SeB-NPs were decreased, which proved the incorporation of SeO32− group. This inclusion was due to the different shape between SeO32− group (trigonal pyramids) and PO43− group (tetrahedra), and phosphate-to-selenite substitution resulted in paired Ca2+ and OH− vacancies to rebalance the charge57. As the Ca/Se mole ratio decreased, the corresponding crystallinity increased. However, the crystallinity of AgSeB-NPs with different AgNO3 concentrations changed slightly, mainly because silver nanoparticles were only deposited on the surface of SeB-NPs without chemical reaction occurred, which was consistent with the UV–Vis DRS testing results. Rameshbabu et al. identified that silver could influence the crystallinity of HA via heat treatment and further changed the nanosize of HA55. Furthermore, the morphology of SeB-NPs showed a typical needle-like bundle shape, which was different from BCP-NPs (Fig. 6 and Figure S1, Supplementary Materials). Unfortunately, the strong tendency to agglomerate made it impossible to evaluate its size distribution. After the deposition of silver, the morphology of AgSeB-NPs tended to be further aggregated, and AgSeB-NPs changed to snowflake-like agglomerate with increasing AgNO3 concentration. Element mapping analysis confirmed that selenium was uniformly distributed in SeB-NPs, and silver was spread on the surface of AgSeB-NPs (Figs. 6 and 7).
Selenium has been widely applied in diverse areas such as the food and pharmaceutical industries. Many studies have confirmed that selenium doped HA not only exhibited low cytotoxicity for osteoblastic cells but also reduced the chance of tumor recurrence24,29. It was necessary to estimate the toxicity of the obtained SeB-NPs and AgSeB-NPs for further tissue engineering applications. Osteoblasts were commonly used to evaluate the cytocompatibility of nanoparticles and/or scaffold in tissue engineering58,59. In this study, the cytocompatibility of SeB-NPs and AgSeB-NPs was assessed by culturing with hFOB 1.19 cells. BCP-NPs possessed excellent cytocompatibility, and the incorporation of selenium into BCP-NPs did not reduce the cellular biocompatibility60. According to CCK-8 analysis (Fig. 8), osteoblasts proliferated with SeB-NPs over days, and the growth of cells was not influenced by the Ca/Se mole ratio. After the deposition of silver, cells cultured with all AgSeB-NPs samples had similar proliferation profiles compared with SeB-NPs. Not only can the addition of selenium and silver improve the growth of the cells with BCP-NPs, but the antibacterial activity was acquired, which has potential for infection-resistant replacement materials61,62.
Finally, the typical Gram-positive S. aureus and Gram-negative E. coli bacteria were used to evaluate the antibacterial activity of synthesized SeB-NPs and AgSeB-NPs. S. aureus, the most common virulent pathogen, and due to the biofilm formation and documented antibiotic resistance, can cause bone-implants-associated infections in hospitalized patients. Here, S. aureus was used together with E. coli (due to the highly capable of reduction)63. Selenium could promote the formation of superoxide radicals and, enhance oxidative stress, which resulted in the damage of bacterial cell walls64 Besides, selenium could inhibit the biofilm formation of the S. aureus and the growth of E. coli65,66. Figures 9 and 10 illustrated the antibacterial activity of SeB-NPs and AgSeB-NPs against S. aureus and E. coli colonies. It was noted that the introduction of selenium in BCP-NPs could not empower the antibacterial performance on SeB-NPs. Besides, the antibacterial activity of the selenium-doped hydroxyapatite nanoparticles (SeHA-NPs) was investigated herein for comparison (Figures S9 and S10, Supplementary Materials). The results revealed that SeHA-NPs didn’t display inhibitory activity against S. aureus and E. coli, which was slightly different from previous reports58,60. The different results might be due to the varying morphology of SeHA-NPs used in this work, demonstrating that the antibacterial effect of nanoparticles is greatly influenced by the shape and size.
However, after deposition of silver on SeB-NPs, the growth of S. aureus and E. coli were both decreased significantly. Assuming that a large number of silver nanoparticles might be released from AgSeB-NPs, which can inhibit the initial bacterial adhesion and growth, the mechanism of prepared AgSeB-NPs was displayed in Fig. 11. Previous papers reported that the release of silver nanoparticles could be regulated by pH, calcium, and phosphate ion concentrations in the surrounding medium67. Notably, the acidic environment could generate the release of silver nanoparticles. Therefore, because of the growth of oral bacteria under acidic conditions, the future use of AgSeB-NPs could be expanded to dental applications68. Besides, selenium-doped bone mineral nanoparticles performed effective bone tumor inhibition. Thus, AgSeB-NPs has potential advantages in the fabrication of a multifunctional bone scaffold for healing related bone tumor diseases. The balance between biocompatibility and antibacterial properties of AgSeB-NPs, i.e., the excellent cytocompatibility, and productive inhibition activity against bacteria, supported the significance of AgSeB-NPs in biomedical applications. However, future applications require further in vitro and in vivo investigations, including the release profile of silver nanoparticles and selenium.
Conclusions
In summary, a well-developed nanostructured SeB-NPs and AgSeB-NPs with excellent biocompatibility and suitable antibacterial properties were fabricated herein. FI-IR, Raman, XRD and XPS analysis certified that the SeO32− was doped at PO43− position. The needle-cluster-like morphology of SeB-NPs was obtained, and the formed AgSeB-NPs tended to flock together, which was confirmed by TEM. After culturing with hFOB 1.19 cells, both SeB-NPs and AgSeB-NPs behaved excellent cytocompatibility. Next, the Gram-negative E. coli and Gram-positive S. aureus were used to verify that AgSeB-NPs had better antibacterial activity than SeB-NPs. The results obtained support the significance of AgSeB-NPs in diverse biomedical applications.
Data availability
All data generated or analyzed during this study are included in the published article and its Supplementary Materials files and are available from the corresponding author on reasonable request.
References
Banerjee, S. et al. Antimicrobial and biocompatible fluorescent hydroxyapatite–chitosan nanocomposite films for biomedical applications. Colloids Surf. B.171, 300–307 (2018).
Nie, L. et al. Development of chitosan/gelatin hydrogels incorporation of biphasic calcium phosphate nanoparticles for bone tissue engineering. J. Biomater. Sci.30, 1636–1657 (2019).
Zhou, R. et al. Amorphous calcium phosphate nanospheres/polylactide composite coated tantalum scaffold: facile preparation, fast biomineralization and subchondral bone defect repair application. Colloids Surf. B.123, 236–245 (2014).
Liu, Q. et al. Insight into biological apatite: physiochemical properties and preparation approaches. Biomed. Res. Int. 2013, 1–13 (2013).
Kolmas, J. et al. Nanocrystalline hydroxyapatite enriched in selenite and manganese ions: Physicochemical and antibacterial properties. Nanoscale Res. Lett.10, 278 (2015).
Nie, L. et al. Preparation and characterization of dithiol-modified graphene oxide nanosheets reinforced alginate nanocomposite as bone scaffold. SN Appl. Sci.1, 545–561 (2019).
Thuaksuban, N. et al. Effects of polycaprolactone–biphasic calcium phosphate scaffolds on enhancing growth and differentiation of osteoblasts. Biomed. Mater Eng.29, 159–176 (2018).
Zarkesh, I. et al. Facile synthesis of biphasic calcium phosphate microspheres with engineered surface topography for controlled delivery of drugs and proteins. Colloids Surf. B.157, 223–232 (2017).
Nie, L. et al. Hydroxyethyl chitosan-reinforced polyvinyl alcohol/biphasic calcium phosphate hydrogels for bone regeneration. ACS Omega5, 10948–10957 (2020).
Nie, L. et al. In vitro biomineralization on poly(vinyl alcohol)/biphasic calcium phosphate hydrogels. Bioinspir. Biomim. Nano9, 122–128 (2019).
Costerton, J. W. et al. Bacterial biofilms: A common cause of persistent infections. Science284, 1318–1322 (1999).
Wang, Y. et al. Dual functional selenium-substituted hydroxyapatite. Interface Focus.2, 378–386 (2012).
Hajipour, M. J. et al. Antibacterial properties of nanoparticles. Trends Biotechnol.30, 499–511 (2012).
Le, O. B. et al. Antibacterial activity of silver nanoparticles: A surface science insight. Nano Today.10, 339–354 (2015).
Lok, C. N. et al. Silver nanoparticles: Partial oxidation and antibacterial activities. J. Biol. Inorg. Chem.12, 527–534 (2007).
Moritz, M. et al. The newest achievements in synthesis, immobilization and practical applications of antibacterial nanoparticles. Chem. Eng. J.228, 596–613 (2013).
Panáček, A. et al. Silver colloid nanoparticles: Synthesis, characterization, and their antibacterial activity. J. Phys. Chem. B.110, 16248–16253 (2006).
Sirelkhatim, A. et al. Review on zinc oxide nanoparticles: Antibacterial activity and toxicity mechanism. Nano-Micro Lett.7, 219–242 (2015).
Xiu, Z. et al. Negligible particle-specific antibacterial activity of silver nanoparticles. Nano. Lett.12, 4271–4275 (2012).
Zhou, Q. et al. Synthesis and characterization of silver nanoparticles-doped hydroxyapatite/alginate microparticles with promising cytocompatibility and antibacterial properties. Colloids Surf. A.585, 124081 (2020).
Xu, Z. L. et al. Enhanced antibacterial activity and osteoinductivity of Ag-loaded strontium hydroxyapatite/chitosan porous scaffolds for bone tissue engineering. J. Mater. Chem. B.4, 7919–7928 (2016).
Yanhua, W. et al. Selenium-substituted hydroxyapatite nanoparticles and their in vivo antitumor effect on hepatocellular carcinoma. Colloids Surf. B.140, 297–306 (2015).
Kolmas, J. et al. Nanocrystalline hydroxyapatite doped with selenium oxyanions: A new material for potential biomedical applications. Mater. Sci. Eng. C.39, 134–142 (2014).
Sun, J. et al. Monodisperse selenium-substituted hydroxyapatite: Controllable synthesis and biocompatibility. Mater. Sci. Eng. C.73, 596–602 (2017).
Matesanz, M. C. et al. Response of osteoblasts and preosteoblasts to calcium deficient and Si substituted hydroxyapatites treated at different temperatures. Colloids Surf. B.133, 304–313 (2015).
Ramos, J. F. et al. Cytotoxicity of selenium nanoparticles in rat dermal fibroblasts. Int. J. Nanomed. 7, 3907–3914 (2012).
Nastulyavichus, A. et al. Antibacterial coatings of Se and Si nanoparticles. Appl. Surf. Sci.469, 220–225 (2019).
Sardarabadi, H. et al. Selenium nanoparticle as a bright promising anti-nanobacterial agent. Microl. Pathog.126, 6–13 (2019).
Wang, Q. et al. Red selenium nanoparticles and gray selenium nanorods as antibacterial coatings for PEEK medical devices. J. Biomed. Mater. Res. B.104, 1352–1358 (2016).
Nie, L. et al. Macroporous biphasic calcium phosphate scaffolds reinforced by poly-l-lactic acid/hydroxyapatite nanocomposite coatings for bone regeneration. BioChem. Eng. J.98, 29–37 (2015).
Nie, L. et al. Physicochemical characterization and biocompatibility in vitro of biphasic calcium phosphate/polyvinyl alcohol scaffolds prepared by freeze-drying method for bone tissue engineering applications. Colloids Surf. B.100, 169–176 (2012).
Menazea, A., Abdelbadie, A.,Sahar. A. & Ahmed, M. K. Manipulation of AgNPs coated on selenium/carbonated hydroxyapatite/ε-polycaprolactone nano-fibrous via pulsed laser deposition for wound healing applications. Appl. Surf. Sci.508, 145299 (2020).
He, L. et al. Selenium-substituted hydroxyapatite particles with regulated microstructures for osteogenic differentiation and anti-tumor effects. Ceram. Int.45, 13787–13798 (2019).
Ahmed, M. K. et al. Complex relationship between alumina and selenium-doped carbonated hydroxyapatite as the ceramic additives to electrospun polycaprolactone scaffolds for tissue engineering applications. J. Alloys Compd.801, 70–81 (2019).
Bejarano, J. et al. PDLLA scaffolds with Cu- and Zn-doped bioactive glasses having multifunctional properties for bone regeneration. J. Biomed. Mater. Res. A.105, 746–756 (2017).
De, S. R. et al. Towards the design of 3D fiber-deposited poly(-caprolactone)/iron-doped hydroxyapatite nanocomposite magnetic scaffolds for bone regeneration. J. Biomed. Nanotechnol.11, 1236–1246 (2015).
Klemm, A. et al. Grain boundary corrosion in TiO2 bone scaffolds doped with group II cations. J. Eur. Ceram. Soc.39, 1577–1585 (2018).
Lin, Y. et al. Effect of copper-doped silicate 13–93 bioactive glass scaffolds on the response of MC3T3-E1 cells in vitro and on bone regeneration and angiogenesis in rat calvarial defects in vivo. Mater. Sci. Eng. C67, 440–452 (2016).
Martínez-Vázquez, F. J. et al. Fabrication of novel Si-doped hydroxyapatite/gelatine scaffolds by rapid prototyping for drug delivery and bone regeneration. Acta. Biomater.15, 200–209 (2014).
Wang, Y. et al. In vitro and in vivo mechanism of bone tumor inhibition by selenium-doped bone mineral nanoparticles. ACS Nano10, 9927–9937 (2016).
Hoover, S. et al. Silver doped resorbable tricalcium phosphate scaffolds for bone graft applications. Mater. Sci. Eng. C79, 763–769 (2017).
Wang, Y. et al. In vitro study on the degradation of lithium-doped hydroxyapatite for bone tissue engineering scaffold. Mater. Sci. Eng. C66, 185–192 (2016).
Wu, C. et al. Copper-containing mesoporous bioactive glass scaffolds with multifunctional properties of angiogenesis capacity, osteostimulation and antibacterial activity. Biomaterials34, 422–433 (2012).
Zhou, P. et al. Enhanced bone tissue regeneration by antibacterial and osteoinductive silica-HACC-zein composite scaffolds loaded with rhBMP-2. Biomaterials35, 10033–10045 (2014).
Paris, J. L. et al. Fabrication of a nanoparticle-containing 3D porous bone scaffold with proangiogenic and antibacterial properties. Acta. Biomater.86, 441–449 (2019).
Qian, Y. et al. Biomimetic domain-active electrospun scaffolds facilitating bone regeneration synergistically with antibacterial efficacy for bone defects. ACS Appl. Mater. Interfaces.10, 3248–3259 (2018).
Shuai, C. et al. A graphene oxide-Ag co-dispersing nanosystem: Dual synergistic effects on antibacterial activities and mechanical properties of polymer scaffolds. Chem. Eng. J.347, 322–333 (2018).
Zhang, Y. et al. 3D-printed bioceramic scaffolds with antibacterial and osteogenic activity. Biofabrication.9, 25–37 (2017).
Nguyen, T. H. D. et al. Antibacterial properties of selenium nanoparticles and their toxicity to Caco-2 cells. Food Control77, 17–24 (2017).
Lu, H. et al. Biomaterials with antibacterial and osteoinductive properties to repair infected bone defects. Int. J. Mol. Sci.17, 334–352 (2016).
Stevanović, M. et al. 45S5Bioglass®-based scaffolds coated with selenium nanoparticles or with poly(lactide-co-glycolide)/selenium particles: Processing, evaluation and antibacterial activity. Colloids Surf. B.132, 208–215 (2015).
Uskoković, V. et al. One ion to rule them all: The combined antibacterial, osteoinductive and anticancer properties of selenite-incorporated hydroxyapatite. J. Mater. Chem. B.5, 1430–1445 (2017).
Markovic, M. et al. Preparation and comprehensive characterization of a calcium hydroxyapatite reference material. J. Res. Natl. Inst. Stand. Technol.109, 553–568 (2004).
Wang, Q. et al. Nanostructured selenium for preventing biofilm formation on polycarbonate medical devices. J. Biomed. Mater. Res. A.100A, 3205–3210 (2012).
Rameshbabu, N. et al. Antibacterial nanosized silver substituted hydroxyapatite: Synthesis and characterization. J. Biomed. Mater. Res. A.80A, 581–591 (2007).
Wang, Y. et al. Selenite-releasing bone mineral nanoparticles retard bone tumor growth and improve healthy tissue functions in vivo. Adv. Healthc. Mater.4, 1813–1818 (2015).
Ma, J. et al. Preparation and characterization of selenite substituted hydroxyapatite. Mater. Sci. Eng. C.33, 440–445 (2013).
Qin, Y. et al. Bone marrow stromal/stem cell-derived extracellular vesicles regulate osteoblast activity and differentiation in vitro and promote bone regeneration in vivo. Sci. Rep.6, 1–11 (2016).
Tong, S. et al. In vitro culture of hFOB1.19 osteoblast cells on TGF-β1-SF-CS three-dimensional scaffolds. Mol. Med. Rep.13, 181–187 (2016).
Guha, A. K. et al. Mesenchymal cell response to nanosized biphasic calcium phosphate composites. Colloids Surf. B.73, 146–151 (2009).
Rajendran, A. et al. Synthesis phase stability of hydroxyapatite–silver composite with antimicrobial activity and cytocompatability. Ceram. Int.40, 10831–10838 (2014).
Shen, J. et al. Carboxylated chitosan/silver–hydroxyapatite hybrid microspheres with improved antibacterial activity and cytocompatibility. Mater. Sci. Eng. C.78, 589–597 (2017).
Masters, E. A. et al. Evolving concepts in bone infection: redefining “biofilm”, “acute vs. chronic osteomyelitis”, “the immune proteome” and “local antibiotic therapy.” Bone Res.7, 1–18 (2019).
Rodríguez-Valencia, C. et al. Novel selenium-doped hydroxyapatite coatings for biomedical applications. J. Biomed. Mater. Res. A.101A, 853–861 (2013).
Tetteh, A. Y. et al. Transcriptional response of selenopolypeptide genes and selenocysteine biosynthesis machinery genes in escherichia coli during selenite reduction. Int. J. Micro. 2014, 1–11 (2014).
Tran, P. A. et al. Selenium nanoparticles inhibit Staphylococcus aureus growth. Int. J. Nanomed.6, 1553–1558 (2011).
Nakamura, M. et al. Physicochemical fabrication of antibacterial calcium phosphate submicrospheres with dispersed silver nanoparticles via coprecipitation and photoreduction under laser irradiation. Acta Biomater.46, 299–307 (2016).
Selwitz, R. H. et al. Dental caries. The Lancet.369, 51–59 (2007).
Acknowledgements
This research was funded by the National Natural Science Foundation of China No. 31700840, and the Key Scientific Research Project of Henan Province No. 18B430013. This research was supported by the Nanhu Scholars Program for Young Scholars of XYNU. We appreciate Master student Qiaoyun Wu from College of Life Sciences (XYNU), for her works during the manuscript revision stage under such special COVID-19 circumstances. We acknowledge Dr. Kangzhe Cao and Dr Hui Qiao from College of Chemistry and Chemical Engineering (XYNU) for their assistance on Raman Spectroscropy testing. We acknowledge the excellent technical assistance of Qiuju Zhou, Zongwen Zhang, Lingyun Zheng, Peiyin Guo, and Lingling Wang from the Analysis & Testing Center of XYNU.
Author information
Authors and Affiliations
Contributions
M. H. carried out materials preparation experiments. M. S. performed the physicochemical characterization. R. H. carried out the in vitro experiments, and T. W. was responsible for antibacterial experiments. L. N. performed the data analysis and manuscript preparation. L. N., M. H., T. W., M. S., and R. H. made a substantial contribution to acquisition and interpretation of data. All authors critically read and approved the final submitted manuscript.
Corresponding author
Ethics declarations
Competing interests
The authors declare no conflict of interests.
Additional information
Publisher's note
Springer Nature remains neutral with regard to jurisdictional claims in published maps and institutional affiliations.
Supplementary information
Rights and permissions
Open Access This article is licensed under a Creative Commons Attribution 4.0 International License, which permits use, sharing, adaptation, distribution and reproduction in any medium or format, as long as you give appropriate credit to the original author(s) and the source, provide a link to the Creative Commons licence, and indicate if changes were made. The images or other third party material in this article are included in the article's Creative Commons licence, unless indicated otherwise in a credit line to the material. If material is not included in the article's Creative Commons licence and your intended use is not permitted by statutory regulation or exceeds the permitted use, you will need to obtain permission directly from the copyright holder. To view a copy of this licence, visit http://creativecommons.org/licenses/by/4.0/.
About this article
Cite this article
Nie, L., Hou, M., Wang, T. et al. Nanostructured selenium-doped biphasic calcium phosphate with in situ incorporation of silver for antibacterial applications. Sci Rep 10, 13738 (2020). https://doi.org/10.1038/s41598-020-70776-7
Received:
Accepted:
Published:
Version of record:
DOI: https://doi.org/10.1038/s41598-020-70776-7
This article is cited by
-
Fabrication of Nanostructured Surfaces Towards the Prevention of Hospital-Acquired Infection
Journal of Cluster Science (2024)
-
Magnetic separation, sunlight-driven photocatalytic activity, and antibacterial studies of Sm-doped Co0.33Mg0.33Ni0.33Fe2O4 nanoparticles
Environmental Science and Pollution Research (2024)
-
Antimicrobial Potency of Green Synthesized Silver Nanoparticles from Stem Extract of Euphorbia poissoniion Urinary Tract Pathogens
Chemistry Africa (2023)
-
Advancing strategies towards the development of tissue engineering scaffolds: a review
Journal of Materials Science (2023)
-
Antimicrobial potential and osteoblastic cell growth on electrochemically modified titanium surfaces with nanotubes and selenium or silver incorporation
Scientific Reports (2022)